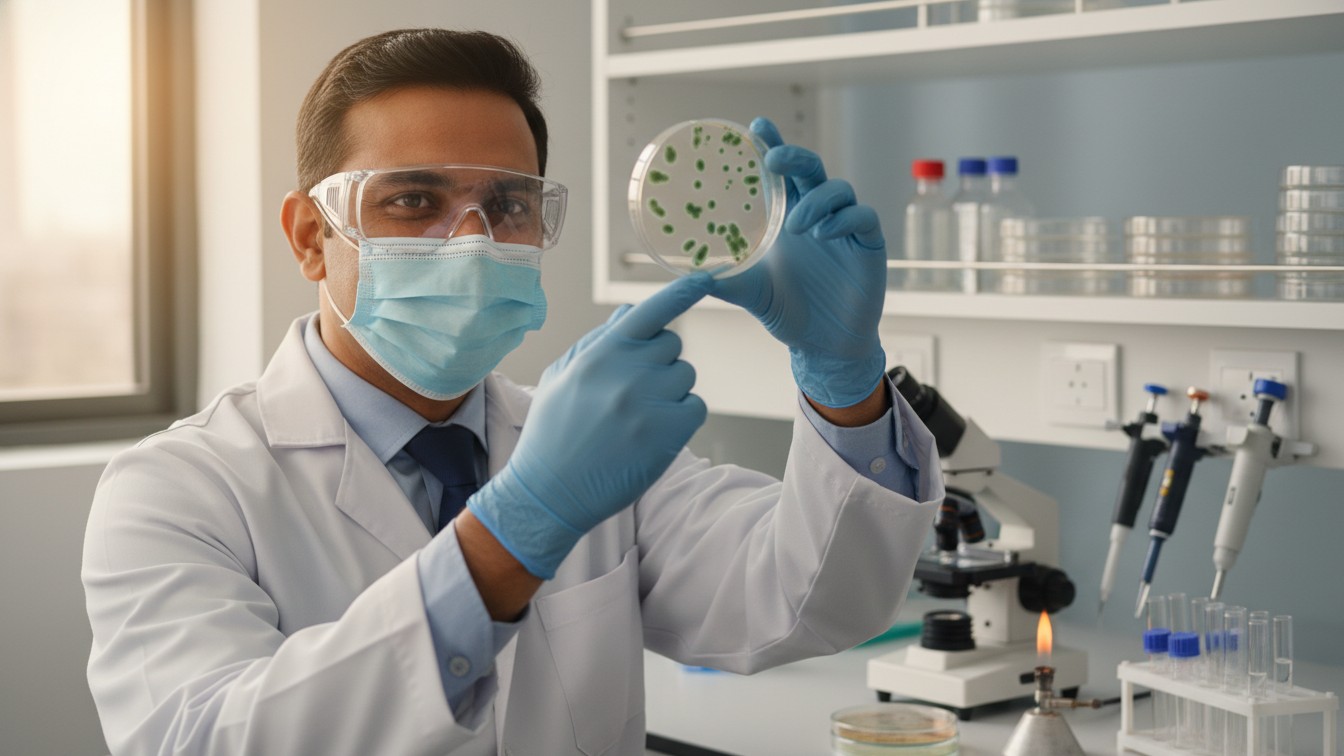
jamil nihal

Precision Lab for Microbial
Discovery & Diagnostics
Welcome to the Lab. If you’ve ever felt the quiet thrill of spotting a bacterial colony you cultured yourself, you’re in the right place.
Journey Through the Petri Dish
The Lab wasn’t born in a lecture hall; it began at a cluttered bench under flickering fluorescent lights. I was training in a high-pressure hospital setting that left me exhausted and detached. I missed the quiet thrill of discovery—the scent of autoclaved agar, the gleam of Gram-stained slides, the hum of an incubator.
I started this site as a simple log of my late-night cultures, a way to reclaim my scientific passion. Slowly, it evolved into a hub for microbiologists, students, and researchers who, like me, seek precision and purpose in every petri dish. What began as solitary experiments has become a dialogue on advancing diagnostics, one colony at a time.
Our Philosophy
“We believe microbiology is not an elite skill for PhDs alone—it’s a practice, a discipline, and a pursuit of truth. In a world of hasty diagnoses, culturing a precise colony is a radical act of focus. It grounds us, reveals pathogens, and affirms our scientific capability.”
What You’ll Find Here
Lab & Cultures
Step-by-step protocols for lab techniques from Gram staining to bacterial cultures. Accessible methods yielding research-grade results.
Inspiration
Honest reflections on lab life, discovery, and beauty in microscopic worlds. Stories of the meticulous, wondrous process of scientific becoming.
Microbial Workspace
Inspiration for your lab bench, research station, or that crowded corner where microbial magic happens.
Lab Life
Navigating the path of a microbiology career. Finding your niche and balancing lab demands with discovery.

Hi, I’m M. Jamil
I’m the microbiologist, researcher, and educator behind the Lab. My passion for microbes ignited in a dimly lit hospital lab, watching colonies emerge from invisible broths into vibrant worlds. There was magic on that bench—not just in the identifications, but in the quiet power of decoding disease.
Today, I’m a strong black coffee enthusiast, avid collector of vintage pipettes and glassware from bygone eras, and a firm believer in the thrill of a perfectly sterile field where discovery awaits. My days seamlessly blend meticulous Gram staining, advanced culture protocols, antibiotic sensitivity testing, and the endless chase for that crystal-clear microscopy view revealing hidden microbial secrets. I created this digital lab space as the mentor I desperately needed early in my career—a trusted guide who hands you the inoculation loop, the staining rack, or the PCR tube and confidently says, “You’ve got this—let’s culture greatness together.”
A Note to the Reader
Whether you’re here to master your first Gram stain or find inspiration over morning coffee, I’m honored you’ve chosen this lab. I hope it inspires you to loop a culture, peer through the scope, or view microbes with wonder. Let’s decode discovery together.
Say hello